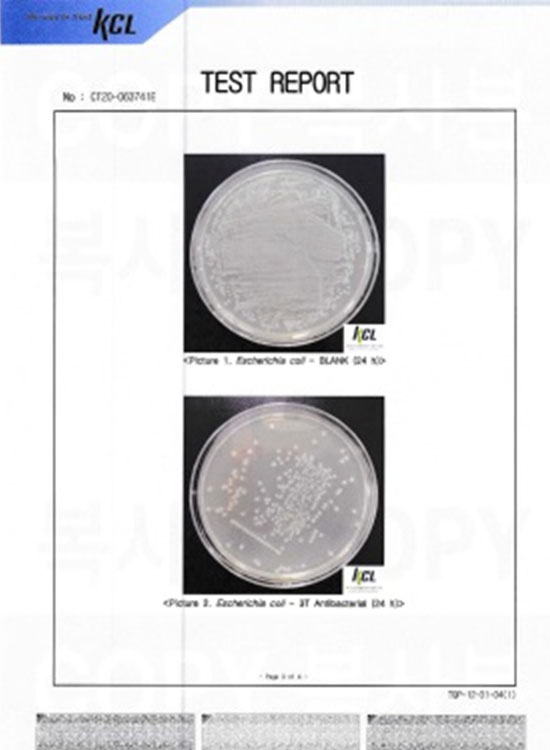
½ÃÇ輺Àû¼
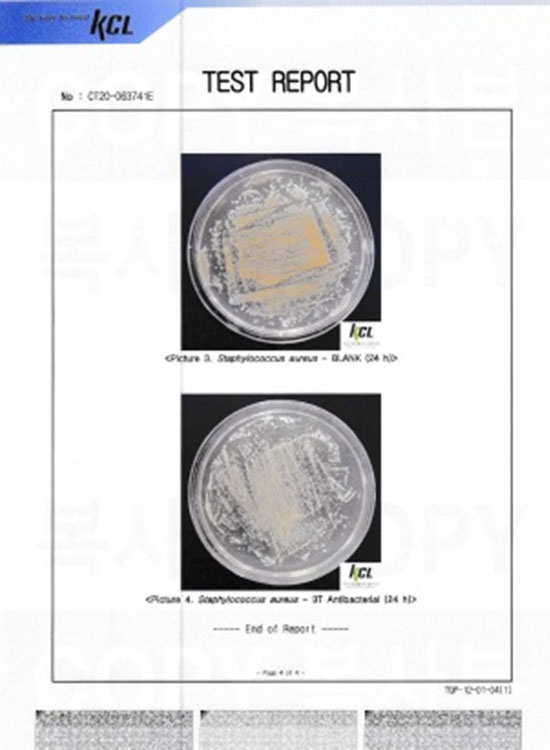
½ÃÇ輺Àû¼

We Will Do Our Best Just Like We Did in the Beginning.
AG+AB Glass (Anti-Glare+Anti-Baterial Glass)
AG+AB Glass is a glass with an antibacterial function added to conventional AG glass.
The demand for anti-bacterial touch glass is on the rise, due to COVID 19.
AG+AB Glass can be applied to large and small-sized touch monitors such as digital whiteboards by coating AG glass with an anti-bacterial solution.
AG+AB Glass can eradicate more than 99% of Staphylococcus aureus and Escherichia coli.
Kiosks, ATMs, and touch screens that are touched by unspecified people hundreds of times a day can carry myriads of germs.
In particular, kiosks are increasingly being used in many places, such as hospitals, banks, airports, and fast food restaurants, increasing the possibility of disease spread through contact with kiosks.